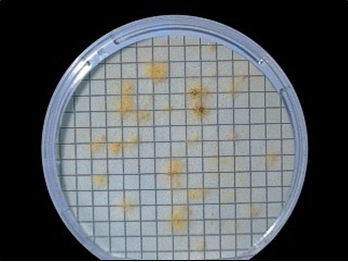
Aspergillus niger en placa con cartón absorbente

SABOURAUD POLIMICOLOGICAL BROTH
sabouraud-polimicological-broth, el caldo sabouraud enriquecido con factores dopping que lo hacen mucho más efectivo que el clásico
Enriquecimiento selectivo de levaduras y mohos, aislamiento más sensible por MF.
COMPOSICIÓN
- Polipeptona micológica 10 g
- Dextrosa 20 g
(Fórmula por litro)
pH final: 5,7 ± 0,2
PREPARACIÓN
Disolver 30 g en 1 litro de agua destilada. Autoclavar a 121 ºC durante 15 minutos.
PARA USO EXCLUSIVO EN LABORATORIO.
AGITE EL BOTE ANTES DE USAR.
MANTENGA EL BOTE BIEN CERRADO EN LUGAR SECO, FRESCO Y OSCURO.
DESHIDRATADO CODIGO: DMT105
sabouraud-polimicological-broth
CONTROL DE CALIDAD DEL MEDIO
Realizado en nuestro laboratorio; es prudente repetirlo en su laboratorio siempre que varíen las condiciones (más de 3 meses sin usar, tras desinfectar laboratorio, tras conservar a alta Tª, cuando adquiere aspectos extraños aunque no haya llegado la fecha de caducidad teórica de la etiqueta,…)
DESHIDRATADO: Polvo grueso, Beige
PREPARADO: Estéril, Ambar
CONTROL DE CRECIMIENTO 3-5 días a temperatura ambiente (21-28°C aproximadamente):
- Staphylococcus aureus MKTA 6538P, Parcialmente inhibido.
- E.coli MKTA 25922, Parcialmente inhibido.
- Aspergillus niger MKTA 16404, Correcto, Colonias negras y esporuladas floculando o flotando en 5 días.
- Candida albicans MKTA 10231, Correcto.
- Saccharomyces cerevisiae MKTA 9763, Correcto.
PRESENTACIÓN: TUBOS PREPARADOS 9 ml, FRASCOS 100 ml, VIALES PARA FILTRACIÓN DE MEMBRANA, MEDIO DESHIDRATADO
NOTA: Preparado como modificación de la USP para enriquecer muestras pobres en hongos y ricas en flora acompañante (ideal para detección en cosméticos) y para detectar levaduras y mohos por la técnica de Filtración de Membrana.
SIEMBRA
Añadir 1 ml o 1 gramo de muestra al tubo o al frasco. Incubar a 21 ºC aproximadamente, durante 3 días (levaduras) o 5 días (mohos). Los viales se añaden sobre cartones absorbentes previamente colocados en placas de Petri de 55 mm de diámetro, y se deposita encima la membrana de filtración.
INTERPRETACIÓN
La turbidez en tubos o frascos indica presencia de hongos. Averiguar por crecimientos coloniales en medios agarizados de qué especies se trata. En el caso de la MF, las colonias aparecidas son de levaduras (colonias no filamentosas) y mohos (colonias filamentosas) aunque a menudo aparecerán colonias de bacterias acompañantes al no ser el medio altamente selectivo.
El usuario final es el único responsable de la destrucción de los organismos que se hayan desarrollado, según la legislación medioambiental vigente.
Si desea más información sobre nuestros SABOURAUD POLIMICOLOGICAL BROTH rellene nuestro formulario de contacto http://www.medioscultivo.com/contacto . O si lo prefiere póngase en contacto con nosotros a través de nuestro correo electrónico microkit@microkit.es o por teléfono en el nº 91-897 46 16
https://www.microkit.es/monograficos/4-Levaduras-y-mohos-monograf–a.pdf